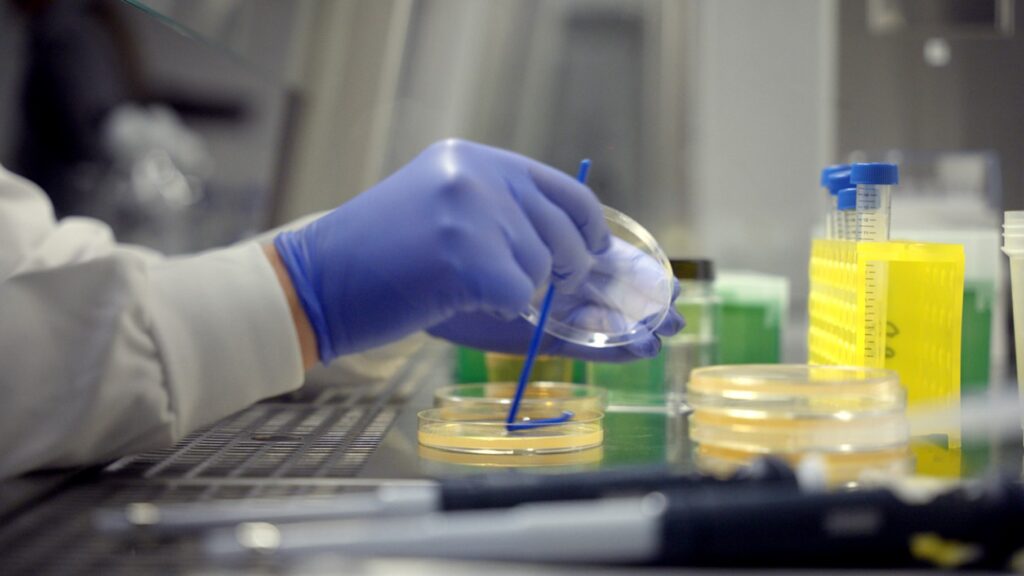

המחקר הגלובלי הראשון של Dyson בנושא ניקוי רטוב חושף תובנות על הרגלי הניקיון בעולם, התסכול משיטות הניקוי הקיימות וחוסר היעילות של שיטות ניקוי מסורתיות
ישראל מובילה את השימוש במכשירי ניקוי רטוב באזור EMEA בישראל, שואבי אבק רטובים ויבשים רובוטיים ושואבי רצפות עומדים נתפסים כמכשירים היעילים ביותר לניקוי רצפות, ומדורגים במקום השלישי בעדיפות הכללית. במדינות ה – EMEA, גרמניה, צרפת, בלגיה וישראל מציגות את השימוש הגבוה ביותר בניקוי רטוב של רצפות בהשוואה לשווקים אחרים שגרת ניקיון בית ממוצעת אורכת כ 109 דקות – כמעט שעתיים!
דייסון מפרסמת את תוצאות המחקר הגלובלי הראשון שלה בנושא ניקוי רטוב,WET STUDY שבחן את הרגלי ניקוי רטוב של רצפות ומשטחים. המחקר, שנערך בקרב 23,311 נשאלים מ-28 מדינות ואזורים שונים, מגלה כי בעוד שבכ-93% מהבתים יש רצפות, רק 48% משתמשים במכשירי ניקוי רטוב לניקוי בתיהם.
לדברי מת'יו לי, מדען מחקר בכיר בדייסון: "בהתבסס על 20 שנות מחקר של דייסון באבק מיקרוסקופי, הממצאים שלנו מאשרים כי שאיבת אבק היא הדרך היעילה ביותר להתמודד עם אבק ביתי". עם זאת, כשמדובר בכתמים עקשניים ויבשים, ניקוי רטוב חיוני כדי להסירם ביתר קלות".
למעלה ממחצית מהמשתמשים בניקוי רטוב, ציינו ששמירה על היגיינה והסרת לכלוך הן הסיבות העיקריות לכך. אבל האם הם משתמשים בשיטות היעילות והאפקטיביות ביותר כדי להשיג תוצאות אלו?
כלים ישנים, בעיות חדשות: מדוע מגב וסמרטוט כבר לא יכולים לעמוד בקצב של הבתים המודרניים?
שיטות ניקוי רטוב מסורתיות לרצפות נותרו הבחירה המועדפת עבור משקי בית רבים, כאשר 52% עדיין מסתמכים על סמרטוט ודלי, 41% משתמשים במטלית לחה ו-24% פונים למטאטא רטוב. עם זאת, כלים אלה מתקשים לעתים קרובות לספק תחושת ניקיון אמיתי- כזה שאפשר ללכת עליו יחפים.
"עבור כלים מסורתיים כמו מגבים, מטאטאים רטובים ומכשירי ניקוי רטוב עם גליל בודד, הבעיה היא שלעתים קרובות נוצרת שכבה של לכלוך או זוהמה בלתי נראים שנמרחים על הרצפות במהלך הניקוי. זה קורה כאשר משתמשים במגב עם מים מלוכלכים או כאשר מכשירי ניקוי לא מצליחים להרים לחלוטין את הלכלוך מהרצפה. לעומת זאת, ה- ™Dyson WashG1 משתמש במערכת גלגלת כפולה כדי להשיג רצפות ללא כתמים", אומר קיטן פאטל, מנהל עיצוב בכיר בדייסון.
45% מהאנשים שמבצעים ניקוי רטוב אומרים שהם צריכים לשאוב אבק או לטאטא את הרצפה לפני שהם מתחילים בפעולת הניקוי רטוב. זה נפוץ בעיקר בסמרטוטים ומטליות לחות, שלעתים קרובות מתקשים להסיר לכלוך גס או שאריות מוצקות. לכן, זה יכול להכפיל את זמן הניקוי הנדרש, ולדרוש שאיבת אבק וניקוי רטוב בשלבים נפרדים.
אין זה מפתיע, אם כן, ששגרת ניקיון בית ממוצעת אורכת כ 109 דקות – כמעט שעתיים! עבור משקי בית עמוסים, מדובר בזמן ממושך מאוד שמדגיש את הצורך בפתרון יעיל יותר המשלב ניקוי יבש ורטוב בצורה חלקה.
תסכולים עיקריים נוספים איתם מתמודדים המשתמשים במכשירי ניקוי רטוב קיימים כוללים:
- כ-1 מכל 3 משתמשים מציין שהכלים שברשותם לא מצליחים לנקות ביעילות את פינות וקצוות הרצפה.
- 1 מכל 4 משתמשים מציין שתחזוקת הכלים גוזלת זמן רב
- 1 מכל 4 משתמשים מציין שהסוללות של המכשירים שלהם לא מספיקות.
- 1 מכל 4 משתמשים מציין על קשיים בהסרת כתמים עיקשיים עם הכלים שברשותם
לפי הסקר, בקרב הצרכנים בישראל, נרשמת העדפה גבוהה לכלים ידניים מסורתיים לניקוי רטוב של רצפות – אך במקביל גם עלייה במודעות ליעילות של מכשירי ניקוי חדשניים, ובראשם שואבים שוטפים (11%).
עוד מצא הסקר כי מבין מדינות ה EMEA, ישראל מדורגת בין המדינות עם רמת המודעות הגבוהה ביותר למכשירי ניקוי רטוב לרצפות. הממצאים מצביעים על שיעור מודעות גבוה של 88%, מה שמעיד על כך כי הצרכן הישראלי מעודכן ומודע לטכנולוגיות מתקדמות.
ומה לגבי סוגי הרצפות בבתים בישראל? מהסקר עולה כי, בישראל, כ־30% מהרצפות נחשבות לרגישות או לכאלו שדורשות הגנה מיוחדת – שיעור גבוה ביחס לממוצע האזורי. עוד נמצא כי רק 40% מהרצפות בישראל הן מסוג עמיד במיוחד בפני שריטות ונוזלים, עם שכבת מגן כגון לכה. 21% מהרצפות דורשות תחזוקה שוטפת ו־9% הן ישנות ועדינות, מה שמעלה את הצורך בפתרונות ניקוי המשלבים יעילות ועדינות גם יחד.
ממריחה לנצנוץ: דייסון ממציאה מחדש את הדרך בה אנו מנקים את הרצפות שלנו
ה-™Dyson WashG1, משלב את המומחיות שלנו במדע האבק והרטיבות, מנקה אבק ולכלוך כמו שואב אבק. זהו השואב השוטף ההיגייני ביותר בשוק, ללא מסננים רטובים וללא פליטת מזהמים משנית העלולים לצבור ריחות וחיידקים. הוא משתמש בשילוב של טכנולוגיות ניקוי והפרדה כדי לאסוף ולהפריד בין פסולת רטובה ליבשה, כולל שיער.
עם שני גלילי מיקרופייבר המסתובבים בכיוונים נגדיים וסופגים במיוחד, ה-™Dyson WashG1 מנקה ביסודיות מכל הכיוונים, מסיר כתמים ב-30% פחות מעברים ומאפשר לרצפות להתייבש 80% מהר יותר מאשר שימוש במגב.
שואב האבק האלחוטי Dyson V15s Detect Submarine™ משלב את תאורת האבק הנסתר של Dyson, שאיבה עוצמתית וטכנולוגיית נגד הסתבכות שיער עם ראש הניקוי הרטוב Dyson Submarine™ לשטיפת רצפות קשיחות. הוא מספק פתרון all-in-one לכל צרכי הניקוי.
ה-Dyson V15s Detect Submarine™, המופעל על ידי מנוע ™Dyson Hyperdymium, מספק שאיבה עוצמתית וניקוי עמוק ומקיף. השואב מגיע עם שלושה ראשי ניקוי הניתנים להחלפה – ה-™Fluffy Optic מאיר אבק בלתי נראה, ה-Digital Motorbar™ מתיר הסתבכות שיער תוך כדי שאיבה, ו-™Dyson Submarine מתמודד עם שפכים, כתמים עקשניים ופסולת בקלות. עם מבנה נמוך ומברשת רחבה , ראש הגליל הרטוב ™Dyson Submarine מאפשר תמרון קל מתחת לרהיטים, ומבטיח שכל פינה, סדק וחלל שקשה להגיע אליו יישארו נקיים ללא רבב.
זכויות יוצרים: המערכת משקיעה מאמצים רבים באיתור בעלי זכויות היוצרים בתכנים המופצים ברבים. במידה ופורסמה מדיה שבעליה אינו ידוע, השימוש נעשה לפי סעיף 27א לחוק זכויות יוצרים. אם הנכם בעלי הזכויות, ניתן לפנות אלינו לצורך הוספת קרדיט או הסרת התוכן.